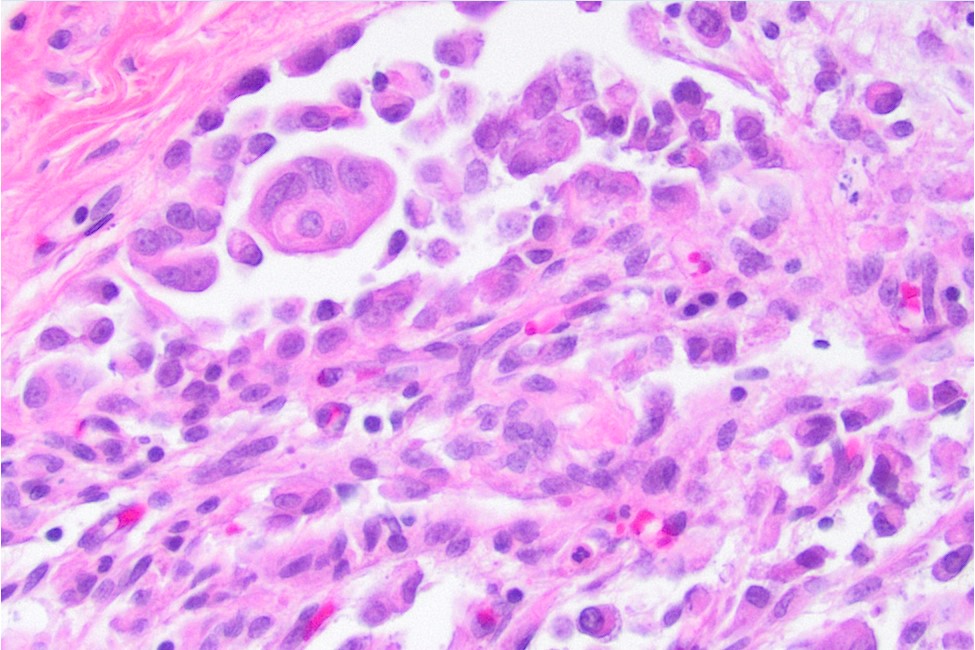

Pericardial Tamponade Due to Metastasis
J. Gael Uy, D.O., Numbereye Numbere, M.D.
Clinical History
A young female child presents with dyspnea and abdominal distension.
Imaging
Retroperitoneal mass with ascites; multiple metastatic tumors of the liver, pancreas, lung, and pericardium (figure 1), and repeated paracenteses due to pericardial tamponade.
Recent History
Histological examination of the patient’s pericardial biopsy specimen revealed infiltration by discohesive pleomorphic rhabdoid cells with prominent pink intracytoplasmic inclusions (figures 2-4), vesicular nuclei with prominent nucleoli, and frequent mitotic figures, including atypical forms. The tumor was positive for the cytokeratin cocktail, EMA, and vimentin. Muscle markers (myogenin and myo-D1), S100, and CD30 were negative (figure 5). There was also a loss of INI-1 immunostaining (figure 6). The findings on cytologic evaluation of the patient’s pericardial fluid were congruent with the histologic findings.